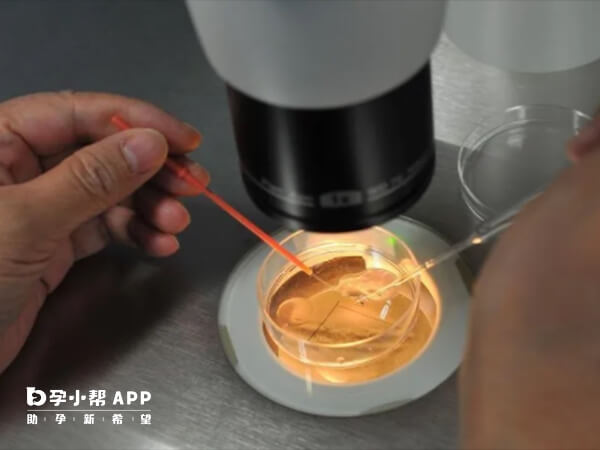
优胚养囊可能会失败

优胚养囊也会失败!有数据表明,第3天的“优质胚胎”,有60%左右发育为囊胚,40%左右不能发育为囊胚,所以囊胚培养过程中会出现优质胚胎也没有形成囊胚的情况。精子或卵子质量、胚胎质量、胚胎发育问题、实验室的环境、胚胎染色体异常等等都是影响囊胚形成的关键因素,任何一个环节出了问题都可能导致养囊失败。
胚胎的评分,只是胚胎学家根据相关指标对胚胎进行的“外貌”综合评估,不是所有的卵裂期胚胎都能形成囊胚,只有生长发育潜能好的胚胎才可以培养成囊胚。所以,优胚不一定能养成优囊,甚至不一定能养成囊胚。通常,养囊失败的原因有以下这些。
1、精子或卵子质量
养囊不是说养就可以养,至少得符合卵泡个数够,胚胎质量优质的条件,否则不建议养囊。
由于养囊对胚胎的质量要求较为严格,而胚胎的原料是精子和卵子,如果精子和卵子一方或双方的质量不好,将直接影响胚胎的质量,这样的胚胎容易停止生长,还没变身为囊胚,就已经全军覆没。 因此,精子或卵子或者胚胎质量不佳的患者,建议尽早移植胚胎,只有子宫才是它们的最佳生存场所。
2、实验室的环境
除了胚胎自身的质量,养囊还要求实验室的氧气、温度保持平衡,幅度稍微有点变化都会改变最终的结局。由于囊胚等级高,发育快,所以着床率基本高于正常胚胎,尤其是对身体情况不便多胎妊娠的患者而言,囊胚的妊娠率更高,而且多胎危险性更低。
3、胚胎发育问题
在囊胚培养过程中,不是所有的卵裂期胚胎都能形成囊胚,只有生长发育潜能好的胚胎才可以培养成囊胚。由于传统形态学评估是根据一定的形态学标准和发育速度(靠“颜值”和“个头”)来选择胚胎,不能准确地预测胚胎的发育潜能,即使是胚胎培养第3天评分为8-9细胞的优质胚胎也有可能不会形成囊胚。
4、胚胎染色体异常
胚胎染色体异常也是囊胚培养失败的一个主要原因。一般来说,夫妻任一方越高龄,胚胎染色体异常的风险越高。有研究表明,染色体异常胚胎的囊胚形成率约为正常胚胎的50%,并且染色体异常程度越严重,囊胚形成率越低。如,胚胎发育速度慢、胚胎多碎片、胚胎多空泡、卵裂球分裂模式异常等。提示胚胎发育潜能偏低。